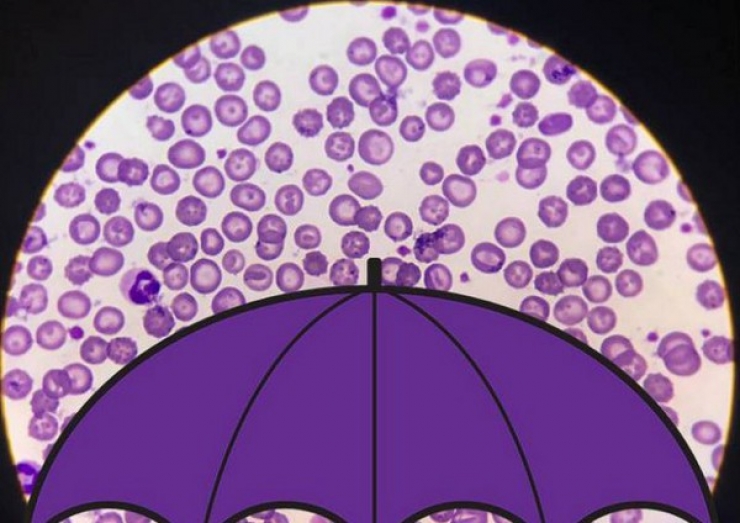

Lo studio è stato concepito per valutare quanto materiale (tra virus e batteri) viene trasportato sopra il cosiddetto "strato limite planetario", ovvero la porzione dell'atmosfera che si estende entro i primi 2-3 chilometri di altezza ed è direttamente influenzata dalla superficie terrestre: a questa altitudine (inferiore a quella a cui volano gli aeroplani) le particelle possono essere trasportate per moltissimi chilometri. Sfruttando dei rilevatori installati in Spagna, sui monti della Sierra Nevada, i ricercatori hanno scoperto che ogni giorno miliardi di virus e decine di milioni di batteri si depositano per metro quadro. I tassi di deposizione dei virus sono risultati essere dalle nove alle 461 volte superiori rispetto a quelli dei batteri. "Circa 20 anni fa - spiega il virologo Curtis Suttle - abbiamo iniziato a trovare virus geneticamente simili in ambienti molto diversi del globo: questa preponderanza di virus persistenti che viaggiano nell'atmosfera probabilmente ci spiega il motivo: è abbastanza plausibile che un virus sollevato nell'atmosfera sopra un continente si possa depositare su un altro". (Ansa)